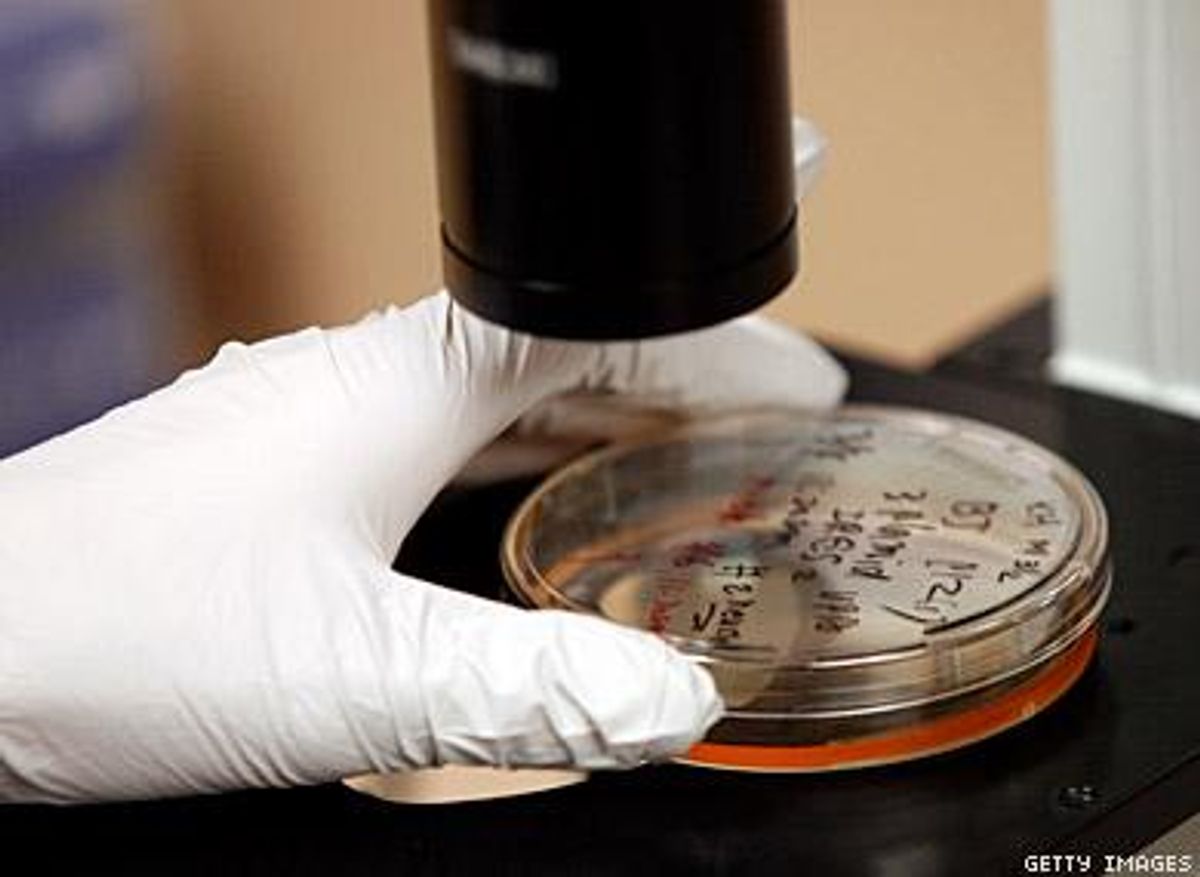
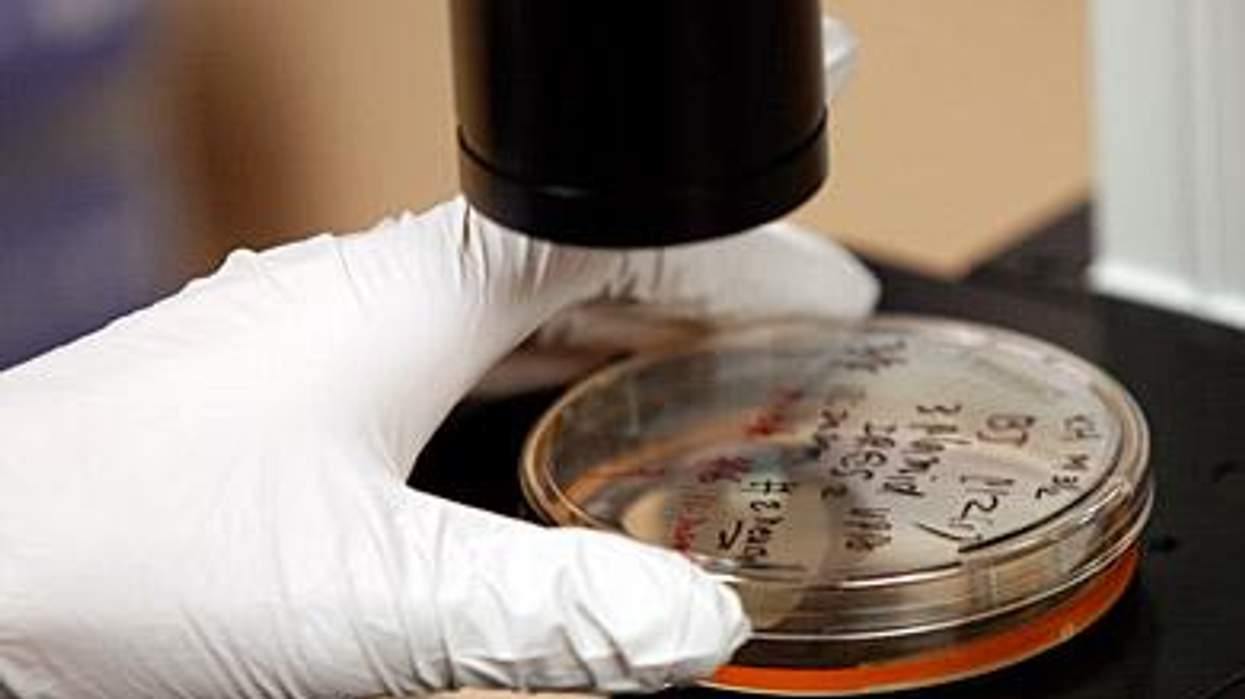
Stem_cellsx390_1

CONTACTStaffCAREER OPPORTUNITIESADVERTISE WITH USPRIVACY POLICYPRIVACY PREFERENCESTERMS OF USELEGAL NOTICE
© 2024 Pride Publishing Inc.
All Rights reserved
All Rights reserved
By continuing to use our site, you agree to our Private Policy and Terms of Use.
Federal funding for human embryonic stem cell research may proceed, a U.S. appeals court ruled Thursday, temporarily striking down an order from a lower court to block funding.
The U.S. court of appeals for the D.C. circuit ordered a temporary stay of the lower court's ruling to end funding. The court, in a one-page order, said the stay would provide its judges with a sufficient amount of time to weigh the Obama administration's emergency motion filed Wednesday to maintain funding the research, according to The Wall Street Journal.
U.S. district court judge Royce Lamberth ruled in August that government-sponsored stem cell research violated a 1996 law.
Some stem cell research focuses on their ability to eradicate HIV from a person's body. In April a 42-year-old man with HIV showed no signs of the virus in his blood after receiving a stem cell transplant with a specific gene mutation two years earlier.
Want more breaking equality news & trending entertainment stories?
Check out our NEW 24/7 streaming service: the Advocate Channel!
Download the Advocate Channel App for your mobile phone and your favorite streaming device!
From our Sponsors
Most Popular
Here Are Our 2024 Election Predictions. Will They Come True?
November 07 2023 1:46 PM
17 Celebs Who Are Out & Proud of Their Trans & Nonbinary Kids
November 30 2023 10:41 AM
Here Are the 15 Most LGBTQ-Friendly Cities in the U.S.
November 01 2023 5:09 PM
Which State Is the Queerest? These Are the States With the Most LGBTQ+ People
December 11 2023 10:00 AM
These 27 Senate Hearing Room Gay Sex Jokes Are Truly Exquisite
December 17 2023 3:33 PM
10 Cheeky and Homoerotic Photos From Bob Mizer's Nude Films
November 18 2023 10:05 PM
42 Flaming Hot Photos From 2024's Australian Firefighters Calendar
November 10 2023 6:08 PM
These Are the 5 States With the Smallest Percentage of LGBTQ+ People
December 13 2023 9:15 AM
Here are the 15 gayest travel destinations in the world: report
March 26 2024 9:23 AM
Watch Now: Advocate Channel
Trending Stories & News
For more news and videos on advocatechannel.com, click here.
Trending Stories & News
For more news and videos on advocatechannel.com, click here.
Latest Stories
Germany makes it easier to change gender and name on legal documents
April 12 2024 6:06 PM
A youth's call to action on this Day of NO Silence
April 12 2024 5:00 PM
Democrats introduce resolution in support of LGBTQ+ youth
April 12 2024 4:35 PM
Colton Underwood is hoping to create a gay reality TV dating show
April 12 2024 4:28 PM
Idaho closes legislative session with a slew of anti-LGBTQ+ laws
April 12 2024 1:39 PM

Pride
Yahoo FeedElevating pet care with TrueBlue’s all-natural ingredients
April 12 2024 1:39 PM
Watch Jimmy Kimmel's hilarious LGBTQ+ campaign video: 'You can't spell Biden without Bi'
April 12 2024 12:00 PM

Pride
Yahoo FeedCreating erotic art and advocacy with adult entertainer Cody Silver (EXCLUSIVE)
April 12 2024 11:39 AM
How I navigated through religious trauma
April 12 2024 11:00 AM
Limited gender markers add hurdles for nonbinary people
April 12 2024 9:34 AM
Suspect in killing of Black trans man Righteous Torrence 'TK' Hill identified by police
April 12 2024 9:13 AM
















































































